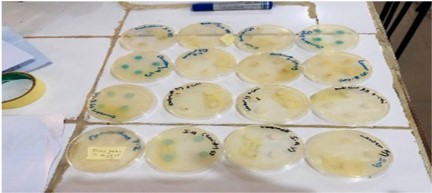

Formulation and Evaluation of Antimicrobial Herbal Soap Incorporating Bioactive Compounds from Azadirachta indica (Neem)
| Received 14 Oct, 2025 |
Accepted 10 Dec, 2025 |
Published 11 Dec, 2025 |
Background and Objective: Synthetic soaps often contain harsh chemicals that can cause skin irritation and environmental pollution. To promote a safer and more sustainable alternative, this study focused on the formulation of herbal soap using Azadirachta indica (neem) leaf extract, known for its antimicrobial and therapeutic properties. The main objective was to produce an eco-friendly soap and assess its physicochemical properties and antimicrobial efficacy against selected pathogenic microorganisms. Materials and Methods: Fresh neem leaves were collected from the Federal Polytechnic Kaura Namoda campus and subjected to ethanol extraction to obtain the crude extract. Herbal soaps were formulated using varying concentrations of neem extract (10, 20, and 30%). Phytochemical screening was performed to identify active compounds, while physicochemical parameters such as moisture content, total fatty matter, free alkali, free fatty acid, chloride content, pH, foam height, and hardness were determined according to ISO/AOAC standards. Antimicrobial activity was assessed against Staphylococcus aureusand Escherichia coli using the agar diffusion method, and inhibition zones were measured to determine the efficacy of each soap concentration. Results: Phytochemical analysis revealed the presence of alkaloids, tannins, saponins, terpenoids, and phenols in the crude extract. All physicochemical parameters of the formulated soaps were within ISO/AOAC standard limits. The antimicrobial test showed that inhibition zones increased with higher concentrations of neem extract. Against E. coli, inhibition zones measured 1.45, 1.46, and 1.65 cm for 10, 20, and 30% concentrations, respectively, while S. aureus exhibited inhibition zones of 1.45, 1.46, and 1.55 cm, respectively. Conclusion: The study demonstrated that Azadirachta indica leaf extract can be effectively utilized to produce eco-friendly herbal soap with notable antimicrobial activity. The 30% neem extract formulation exhibited the highest inhibition against E. coli, confirming its potential as a natural alternative to synthetic soaps. Further research is recommended to optimize formulation stability and assess long-term antimicrobial performance.
INTRODUCTION
Skin infections are mainly caused by bacteria and fungi; the common bacteria are Staphylococcus aureus and Streptococcus species1. These infections are commonly treated with the aid of antibacterial drugs, creams, and anti-inflammatory agents. Other infections, such as eczema, ringworm, and pruritus, are also treated with some succulent gel. Some used chemical substances such as surfactants to clean and wash skin to prevent skin from contagious microorganisms2.
Traditionally, people in rural areas often use various medicinal leaves to cure and prevent skin infections. The method and mode of using these medicinal leaves by villagers are boiling and bath with the extract for skin infections. Azadirachta indica, commonly called the neem tree or neem leaves, appears green as a tropical tree that fund almost everywhere in the Northern part of Nigeria. The leaves and the stems of the need tree are used for different medicinal purposes for both children and adults3.
Several researchers have reported the antimicrobial effect of this neem extract, such as antidermatitic, anti-inflammatory, and other body protective properties. However, the tree is now commonly used for skin infections such as staph and E. coli because of the bioactive phytochemicals present in the neem4.
Therefore, innovating the neem extract to produce called Herbal soap as a vehicle to drive the bioactive compound into the skin tissue for effective use. These soaps are full of natural ingredients, such as essential oils and herbal extracts. The name herbal soap has become popularly accepted as medicinal soap for various skin infections. People love them because of their health benefits, they're environmentally friendly, and they don't contain all the harsh chemicals that regular soap does5.
Many herbal soaps in the market today have a long history of their efficacy toward various skin diseases, most especially pathogens such as fungal and Staphylococcus aureus and other streptococcus species6.
The literature has shown that most herbal soaps formulated by different researchers globally, the neem tree was part of the active ingredient for antimicrobial activities7. Researchers combine these leaf extracts with other proven medicinal plants such as turmeric and Aloe vera extract.
Herbal soaps exert their various mechanisms of action against microorganisms. It penetrates the cell membranes because some of the compounds found in the herbal ingredient are integrated into the microbial cell membrane, therefore, causing the permeability and leakage of cell content to cell death. Herbal soap bioactive compounds can also inhibit the activity of enzymes such as protease and lipase and stop the replication of the microorganism8.
It was reported that the bioactive compound in the herbal soap interferes with biofilm and makes the microorganism more susceptible to eradication. Some herbal bioactive compound generates oxidative stress induction with the microbial cell wall. This action damages the protein, and lipids lead to the death of the cell9.
Several studies have evaluated the efficacy of herbal soaps in clinical and laboratory settings. For instance, a study demonstrated a significant reduction in bacterial load on the skin compared to conventional soaps. Another study found that soap containing tea tree oil effectively reduced the presence of acne-causing bacteria, outperforming standard antimicrobial soaps. Comparative antimicrobial activities of Neem oil and its leaf extract have limited information in the literature10.
Different extracting processes, such as the solvent used, may have also improved the activities of the bioactive compound of these neem extracts or juices11. Prepared a herbal using different plant extracts and found it effective on E. coli. The physiological understanding of the structure and basic functions of the skin, combined with literature evidence of natural and herbal remedies for common skin conditions as shown the importance of herbal soap. The benefit of herbal soap was not recognized until the global research findings showed the activities against various skin diseases. Therefore, ethanol extract of neem leaves and the neem leaves powder were used to produce herbal soap using the cold saponification method; the antimicrobial activities were tested and compared with isolated Staphylococcus and E. coli.
The growing interest in herbal soaps is driven by their perceived safety, natural origin, and potential health benefits. However, despite the popularity and purported antimicrobial properties of herbal soaps, there remain several critical research gaps and challenges. This research would provide information that would be useful in the overview of herbal soap production with various bioactive plants12. The objective of this study was to formulate an eco-friendly herbal soap using Azadirachta indica (neem) leaf extract and to evaluate its phytochemical composition, physicochemical properties, and antimicrobial activity against selected pathogenic microorganisms (Staphylococcus aureus and Escherichia coli).
MATERIAL AND METHODS
Study area and duration: Kaura Namoda is a local government area in Zamfara State, Nigeria. Federal Polytechnic Kaura Namoda is located in that local government. It has 868 km and an estimated population of 881,367 as of 2014. The environment is dominated by plantations of the Neem tree. The Neem tree was locally used for the treatment of different illnesses. The study was carried out from February, 2025 to August, 2025.
Chemicals: All the chemicals and reagents used as purchased, they are of analytical grade. The equipment and materials used were sterilized, calibrated, and kept in a sterilized environment. The apparatus was selected and washed with detergents and rinsed with running tap water, and cleaned with distilled water.
Sample collection: The neem leaves were collected from the Federal Polytechnic Kaura Namoda main campus into a sterilized polytene bag.
Extraction of bioactive compounds from neem leaves: The fresh neem leaves were cleaned with distilled water and spread in the laboratory for shade drying at room temperature. This process was chosen to prevent heat-sensitive compounds from damage at high temperatures. After 5 days, the dried material was ground to a fine powder with the aid of a laboratory mortar and pestle.
Cold extraction (Maceration) was used as described by 100 g of the dried neem leaves was weighed and 70% ethanol was also added in a sealed 1000 mL capacity conical flask. This was kept at room temperature for 72 hrs with regular shaking. The solution was then filtered using Whatman filter paper number 1 to obtain the cleared filtrate. The filtrate was concentrated to remove the excess ethanol using a water bath at low temperature to evaporate the ethanol, and the semi-solid crude extract was used as a herbal ingredient for the soap production.
Soap production using cold processes: The cold process of making soap is a common method for soap-making techniques. It is simply the process of mixing fat/oils with a strong alkali, such as sodium hydroxide, at room temperature, called saponification. An appropriate weight of sodium hydroxide was weighed and dissolved in distilled water, and kept for 24 hrs. after that, the hydrometer gauge was used to determine the recommended value for soap production. The concentration of neem extract added varies in different concentrations in each soap production, ranging from 30, 40 and 50% neem extract. The herbal soap was kept for 5 weeks in a dry place to allow it the harden.
Physicochemical assessment of herbal soap: The physicochemical assessment was carried out on the herbal soap produced, weight of the herbal soap, form height, form retention, and pH. The weight of the herbal soap was determined using a digital weighing balance to determine the actual weight of each herbal soap produced.
Form height was determined by weighing 1 g of the herbal soap sample dissolved in 30 mL of distilled water in a cleaned, calibrated measuring cylinder. The 50 mL of distilled water was added and allowed to stand still until the aqueous layer was measured on each measuring cylinder and recorded. Form retention was also carried out by preparing 25 mL of 1% herbal soap samples into a cleaned measuring cylinder and shaking for 5 times, of each shake, the height was measured for about five times in 1 min intervals.
|
The pH test was carried out using a pH meter. The 0.5 g of each herbal soap was dissolved in distilled water, the digital pH meter electrode was immersed in the soap solution, and the reading was taken for each soap solution.
Antimicrobial activities of the herbal soap: The test organisms used for this analysis were clinically isolated Staphylococcus aureus, Escherichia coli. The test organisms were prepared by streaking on a freshly prepared nutrient agar plate to obtain discrete colonies. A colony was picked with the aid of a sterile wire loop and transferred into a bottle containing sterile normal saline. the turbidity was compared with that of a McFarland turbidity standard scale 0.5, which is equivalent to a bacterial cell density of 1.5×108 CFU/ML7.
Determination of inhibitory activity of the soaps using the agar well diffusion method: Freshly prepared agar (20 mL) was prepared according to the method described by Aliyu et al.7, poured into sterile Petri-dishes, and the agar was allowed to solidify (gel). The bacterial strains were swabbed on the Nutrient agar plates. Four wells, each of diameter 6 mm, were made into each agar plate using a cork borer, and the plates were labeled. Unto each plate, 0.2 mL of appropriate soap dilution was placed in appropriate wells, that is, 300, 200, 100, and 50 mg/mL, respectively. The plates were left for 1 hr for the herbal soap to diffuse into the agar and then incubated at 37°C for 24 hrs. After incubation, the plates were observed for evidence of inhibition (zone of inhibition). The diameters of the wells were measured using a calibrated ruler in cm. The experiment was performed in duplicates, and the averages were calculated.
Figure 1 shows the culture plate of test organism with the produced soap solution. All the culture plate was label for easy identification of growth against the soap solution.
RESULT AND DISCUSSION
The susceptibility of the two microorganisms (S. aureus and E. coli) to various concentrations of neem extract used in the herbal soaps is shown in Table 1.
Table 1 above shows the inhibition zone measured in (cm) against 10, 20 and 30% concentration of neem extract used for the preparation of the herbal soap. The test organisms used were E. coli and S. aureus; the inhibition zone was measured as shown in the Table 1.
The 10% extract concentration has an inhibition zone of 1.45 on E. coli and S. aureus. The 20% neem extract showed a high inhibition zone on S. aureus (1.55 cm) and (1.46 cm) on E. coli. The 30% neem extract of herbal soap has a high inhibition zone on E. coli (1.65 cm) and on S. aureus (1.58 cm). The statistical tool shows a significant difference among the different concentrations of Neem extract used in the preparation of the herbal soap. The antimicrobial activities of Neem extract have proven its efficacy on the E. coli and S. aureus, as it was also reported7 that herbal soap was prepared combination of different extracts, such as Neem extract and lemon grass1. Also reported the efficacy of Neem leaves extract on some bacterial species. Azadirachta indica is grown in all parts of the world because of its medicinal value as proven by different researchers10. The antibacterial activities of Neem herbal soap produced for, the Neem oil shows effectiveness on Staphylococcus aureus and Escherichia coli.
| Table 1: | The result of inhibition of herbal soap with 10% neem extract on the bacterial | |||
| Test organism | 10% Neem extract of herbal soap |
20% Neem extract of herbal soap |
30% Neem extract of herbal soap |
| E. coli | 1.45 cm | 1.46 cm | 1.65 cm |
| S. aureus | 1.45 cm | 1.55 cm | 1.58 cm |
| E. coli: Escherichia coli and S. aureus: Staphylococcus aureus | |||
| Table 2: | Quantitative determination of phytochemical test on the crude neem extract | |||
| Phytochemical | Test | Observation | Inference |
| Alkaloid | Dragendorff’s | Orange brown | Positive |
| Flavonoids | Shinoda test | No visible change | Negative |
| Phenol | Ferric Chloride test | Deep blue coloration | Positive |
| Glycoside | Keller-Killiani test | No visible change | Negative |
| Terpenoid | Salkowski test | Golden yellowish | Positive |
| Tannins | Ferric chloride test | Blue-black coloration | Positive |
| Table 3: | Physiochemical evaluation of herbal soap produced | |||
| Parameter | Method | H.S1 | H.S2 | H.S3 | ISO/AOAC STD value |
| M. C (%) | Oven dried (105) | 12% | 12% | 12% | 10-15% |
| TFM (%) | Titrimetric | 78% | 75,8% | 74,7% | 76% |
| F.A (%) | Titrimetric | 0.21% | 0.22% | 0.18% | 0.10% |
| F.F.A (%) | Titrimetric | 1.60% | 1.56% | 1.48% | 0.5-2.0% |
| Chloride content (%) | Mohr’s method | 0.80% | 0.80% | 0.78 | 1.00% |
| pH | pH meter | 10.5 | 10.7 | 10.8 | 09-Nov |
| F.H | Shake method (cylinder) | 130 mm | 135 mm | 140 mm | >150 mm |
| Hardness | Penetration test | Not crumble | Not crumble | Not crumble | - |
| Insoluble alcohol matter (%) |
Extraction method (using ethanol) |
0.21% | 0.34% | 0.56% | <2.0% |
| M.C: Moisture content, TFM: Total fatty matter, F.A: Free alkali, FFA: Free fatty acid, F.H: Form height and H.S1: Herbal soap | |||||
Another study Shinde and Somani10, developed Neem herbal soap with the combination of Tulsi powder. In their report, the herbal soap was proven effective on dermatophyte.
Herbal soap prepared using Azadirachta indica and Ocimum sanctum, they concluded in their report that the combination has potential for antibacterial and antioxidant11. A study Mokate et al.11 formulated and evaluated the neem herbal soap in India. They reported the action of producing herbal soap as very effective on anti-inflammatory, antihyperglycemic, antibacterial, and antifungal.
In the findings by the global researchers, Azadirachta indica has proven its antimicrobial activities to be very effective on different kinds of skin diseases. The only variation on each finding by the different researchers is the method of extraction of these Neem leaves, the concentration extract used, and the path of the Neem tree used to prepare the herbal soap.
From the Table 2 above, quantitative test for the present of phytochemical compound present from the neem leaves extract used for the formulation of herbal soap. The quantitative test shows the present of Alkaloid, phenol, terpenoid and tannins while flavonoid and glucoside were absent. Phytochemical terms as a natural chemical compound that mostly found in plant. The have antimicrobial activities12. The antimicrobial activities of alkaloid7, has ability to interfere and stop the DNA replication or inhibit the
essential enzyme of the microorganism because alkaloid contained nitrogen compound. Polyphone compound has also term as phytochemical that contained hydroxide groups, the activities of this compound interfere with cell membranes of the microorganism because it causes the denaturation of microbial cell protein. On the other hand, the present of terpenoid in crude extract of the neem leaves shows it ability to penetrate the lipid bilayers of the microorganism which in turn increase the permeability of the cell. The action of terpenoid as also reported by Mokate et al.11 that it can cause oxidative stress and inhibit the enzyme responsible for microbial respiration. Finally, Tannin was quantitatively present in the crude Neem leave extract. This also proven the evidence of herbal soap antimicrobial activities, because tannin bind to protein cell wall of microorganism and result to the inactive cell adhesion13.
Table 3 shows the physicochemical evaluation of herbal soap produced from the neem leaf extract with different concentrations of the extract, 10, 20 and 30% as shown in Table 3. The following parameters were determined, namely: Moisture content, total fatty matter, free fatty acid, chloride content, pH, form height, and hardness. The moisture content of the herbal soap produced falls within the standard value of 10-15% moisture content. The moisture content of soap determines the stability and shelf life.
The total fatty matter, free alkali content, and free fatty acid of the herbal soap produced fall within the standard range value of 76% for toilet soap. The 0,1 and 0.5-2.0%, respectively. However, the high total fatty matter determines the lather of the soap, while high free alkali may cause irritation of the skin. The chloride content, pH, form height, and hardness of the herbal soap produced are within the standard range; however, the chloride content of the soap produced is lower than the standard value, while the pH of the herbal soap falls between 10.5-10.8, which is also within the range of the standard value of 9-11. This is to ensure that soap is safe to use for the skin13.
CONCLUSION
The research evaluates the antibacterial activities of herbal soap produced from different concentrations of the crude. The phytochemical compounds present are alkaloids, Tannin, Saponins, terpenoids, and Phenol. The Physicochemical assessment was also carried out on the herbal soap produced: Moisture content, Total fatty matter, free alkali, free fatty acid, chloride content, pH, Form height, and hardness. A sensitivity assay was carried out on the herbal soap samples to determine the zone of inhibition. The results show a pattern of inhibition that varied with the soap concentration. The inhibition zone of each herbal soap against the test organism is E. coli: 1.45, 1,46, and 1.65 cm for the concentrations of crude extract 10, 20 and 30%, respectively. The inhibition zone against Staphylococcus aureus was 1.45, 1.46, and 1.55cm against the different concentrations of the extract. Therefore, the 30% crude extract used for the production of the herbal soap shows a high sensitivity against E. coli.
SIGNIFICANCE STATEMENT
This study highlights the potential of Azadirachta indica (neem) leaf extract as a natural, eco-friendly alternative to conventional synthetic soaps. By demonstrating both compliance with physicochemical standards and significant antimicrobial activity against common pathogens, the findings provide a sustainable solution to reduce chemical exposure and environmental pollution while promoting public health. The results may inform future development of herbal personal care products with enhanced safety and efficacy.
ACKNOWLEDGMENT
The Authors acknowledge the Tertiary Education Trust Fund (TETFUND) through the Management of Federal Polytechnic Kaura Namoda, Zamfara State, Nigeria, for the Sponsorship of this Research Institutional Base Research (IBR).
REFERENCES
- Pooja, N., P. Mounika, D. Shailaja, N. Rakesh and J. Nandini et al., 2025. Herbal soap formulation and testing for antibacterial and skin lightening properties. World J. Pharm. Med. Res., 11: 371-377.
- Devi, A.S., D.V. Sivani, D. Anusha, G. Sarath and S.M. Sultana, 2021. Formulation and evaluation of antimicrobial herbal soap. Int. J. Pharm. Sci. Rev. Res., 71: 122-125.
- Bernaldez, J.L. and M.C.G. Vicencio, 2021. Antibacterial activity of soap formulated from garlic (Allium sativum L.) extract. J. Adv. Microbiol., 21: 63-67.
- Warra, A.A., I.G. Wawata, R.A. Umar and S.Y. Gunu, 2012. Soxhlet extraction, physicochemical analysis and cold process saponification of Nigerian Jatropha curcas L. seed oil. Can. J. Pure Appl. Sci., 6: 1803-1807.
- Ameh, A.O., J.A. Muhammad and H.G. Audu, 2013. Synthesis and characterization of antiseptic soap from neem oil and shea butter oil. Afr. J. Biotechnol., 12: 4656-4662.
- Kumar, K.H., S. Razack, I. Nallamuthu and F. Khanum, 2014. Phytochemical analysis and biological properties of Cyperus rotundus L. Ind. Crops Prod., 52: 815-826.
- Aliyu, M.S., M.B. Tijjani, M.H.I. Doko, I. Garba and M.M. Ibrahim et al., 2012. Antimicrobial activity of Sabulun salo a local traditional medicated soap. Niger. J. Basic Appl. Sci., 20: 35-38.
- Wylie, M.R. and D.S. Merrell, 2022. The antimicrobial potential of the neem tree Azadirachta indica. Front. Pharmacol., 13.
- Ashraf, A. and K. Rafiq, 2025. Preparation and characterization of antibacterial herbal soap. J. Pharmacogn. Phytochem., 14: 388-397.
- Shinde, M.D. and S. Somani, 2023. Development, design and evaluation of herbal neem soap. Int. J. Pharm. Sci., 1.
- Mokate, R.D., J.S. Kokat, P.B. Aher, A. Kakade, S. Patil and D. Darade, 2024. Preparation and evaluation of herbal antimicrobial soap. J. Pharmacogn. Phytochem., 13: 288-293.
- Tole, S., R. Khaire, S.M.S. Salim and G. Rathi, 2024. Formulation and evaluation of herbal neem soap. Int. Res. J. Modernization Eng. Technol. Sci. 6: 24-29.
- Kumar, R., M.S. Akhtar and M. Gupta, 2023. Formulation and evaluation of herbal neem and turmeric soap. EPRA Int. J. Res. Dev., 8: 91-95.
How to Cite this paper?
APA-7 Style
Shaibu,
M., Orivri,
F.O. (2025). Formulation and Evaluation of Antimicrobial Herbal Soap Incorporating Bioactive Compounds from Azadirachta indica (Neem). Asian Journal of Emerging Research, 7(1), 104-110. https://doi.org/10.3923/ajer.2025.104.110
ACS Style
Shaibu,
M.; Orivri,
F.O. Formulation and Evaluation of Antimicrobial Herbal Soap Incorporating Bioactive Compounds from Azadirachta indica (Neem). Asian J. Emerg. Res 2025, 7, 104-110. https://doi.org/10.3923/ajer.2025.104.110
AMA Style
Shaibu
M, Orivri
FO. Formulation and Evaluation of Antimicrobial Herbal Soap Incorporating Bioactive Compounds from Azadirachta indica (Neem). Asian Journal of Emerging Research. 2025; 7(1): 104-110. https://doi.org/10.3923/ajer.2025.104.110
Chicago/Turabian Style
Shaibu, Momoh, and Francisca O. Orivri.
2025. "Formulation and Evaluation of Antimicrobial Herbal Soap Incorporating Bioactive Compounds from Azadirachta indica (Neem)" Asian Journal of Emerging Research 7, no. 1: 104-110. https://doi.org/10.3923/ajer.2025.104.110

This work is licensed under a Creative Commons Attribution 4.0 International License.



